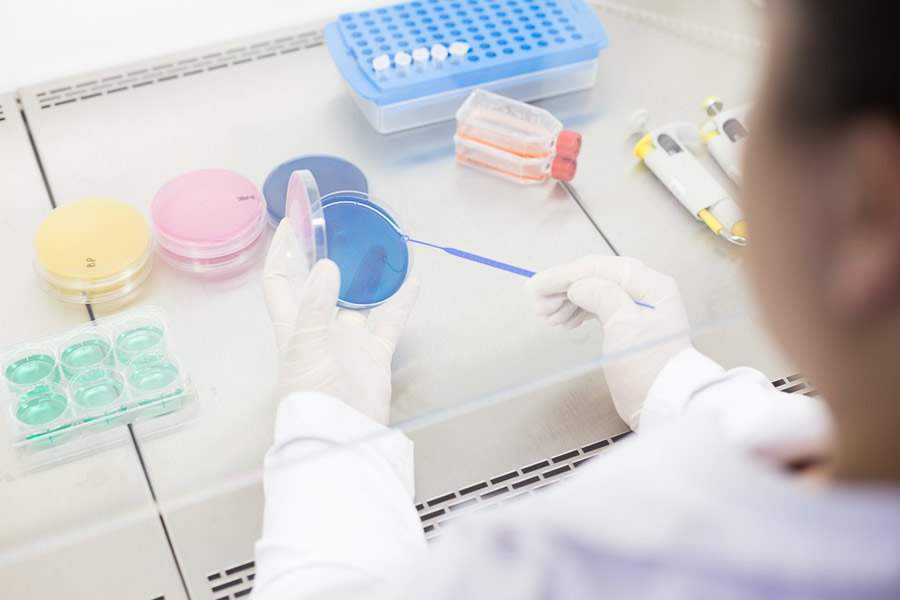

Dica de milhões: Observe a higienização do isopor antes de consumir latinhas e garrafas de água no bloquinho
É necessário tomar alguns cuidados para que a festa não acabe com antecedência devido a uma doença gastrointestinal
Professora de Biomedicina explica como consumir latinhas e garrafas de água com segurança
Apesar dos riscos de contaminação ao beber diretamente na garrafa ou lata, com cuidados básicos de higienização nada vai atrapalhar a folia
O vai e vem dos bloquinhos já começou pelas ruas de todo País. São trios elétricos, blocos, shows, desfiles de agremiações em um universo de atrações que movimentam os amantes do carnaval. No meio da folia, dificilmente é possível correr para um bar ou restaurante para comprar garrafinhas de água ou latinhas de bebida e o jeito mais rápido e prático é recorrer aos vendedores ambulantes na hora de matar a sede. Mas é necessário tomar alguns cuidados para que a festa não acabe com antecedência devido a uma doença gastrointestinal. Segundo o Ministério da Saúde, a maioria das doenças gastrointestinais é causada por Salmonella, Escherichia coli e Staphylococcus. Também há surtos provocados por virus, parasitas e, em menor proporção, por substâncias químicas.
A professora do curso de Biomedicina do Centro Universitário São Camilo, Jeane Facioli, explicou que existem riscos de contaminação ao beber diretamente na garrafa ou lata, mas com cuidados básicos de higienização nada vai atrapalhar a folia.
Segundo ela, é fato que nem todo mundo que entra em contato com estes patógenos adoecem. “Nem sempre a presença do microrganismo irá causar doença. Isso acontece por conta da resposta imulonológica da pessoa e por conta da carga bacteriana do produto”, afirmou.
Primeiramente o folião deve observar o gelo utilizado nos isopores dos vendedores ambulantes, que podem propagar uma variedade de micro-organismos se não forem manuseados e/ou armazenados adequadamente. A professora de Biomedicina observou que a água usada na produção do gelo deve atender aos padrões de qualidade da legislação sanitária vigente e que o próprio isopor utilizado para armazenamento das bebidas deve estar devidamente higienizado.
“Vamos pensar que mesmo que a produção desse gelo tenha ocorrido de forma adequada, mas quando ele chegou no ponto de venda o isopor estava sujo ou rachado. É aí que aparece a fonte de contaminação”, alertou.
Ela também deu o exemplo da manipulação das bebidas por mãos não higienizadas. “Isso também é fator crítico que compromete a qualidade do gelo e, se somar ao isopor sujo e gelo feito de água clandestina, o risco é ainda maior. Além disso, tanto para quem vende como para quem compra, as recomendações básicas incluem lavar as mãos antes tocar nos alimentos e bebidas, depois de ir ao banheiro e após o manuseio de objetos sujos, entre outras situações que possam causar infecções e contaminações.
E se acontecer da sede bater no meio da multidão com sol a pino e o jeito for mesmo comprar aquela garrafinha de água supergelada no ambulante mais próximo? Passar a garrafinha ou latinha na roupa resolve?
Não. O consumo da bebida diretamente na embalagem torna o produto uma possível via de proliferação de microorganismos, trazendo riscos de contaminação e transmissão de doenças. A professora Jeane Facioli falou que é preciso observar o isopor e também a higienização por parte do vendedor ao segurar o refrigerante. Caso ele toque no local onde o consumidor põe a boca ao ingerir a bebida pode potencializar o risco do consumo na própria embalagem. Dessa forma é de grande importância a disposição de guardanapos e copos pelo vendedor ambulante, facilitando sua utilização por parte dos consumidores
Uma outra dica é que o folião tenha sempre em mão um pack de lenço desinfetante para passar na latinha. “Se não for possível, ele deve tentar não colocar a garrafa na boca e usar canudos de papel.” São cuidados simples que, se tomados, vão deixar o carnaval mais alegre e saudável.
Compartilhe:: Participe do GRUPO SEGS - PORTAL NACIONAL no FACEBOOK...:
https://www.facebook.com/groups/portalnacional/
<::::::::::::::::::::>
IMPORTANTE.: Voce pode replicar este artigo. desde que respeite a Autoria integralmente e a Fonte... www.segs.com.br
<::::::::::::::::::::>
No Segs, sempre todos tem seu direito de resposta, basta nos contatar e sera atendido. - Importante sobre Autoria ou Fonte..: - O Segs atua como intermediario na divulgacao de resumos de noticias (Clipping), atraves de materias, artigos, entrevistas e opinioes. - O conteudo aqui divulgado de forma gratuita, decorrem de informacoes advindas das fontes mencionadas, jamais cabera a responsabilidade pelo seu conteudo ao Segs, tudo que e divulgado e de exclusiva responsabilidade do autor e ou da fonte redatora. - "Acredito que a palavra existe para ser usada em favor do bem. E a inteligencia para nos permitir interpretar os fatos, sem paixao". (Autoria de Lucio Araujo da Cunha) - O Segs, jamais assumira responsabilidade pelo teor, exatidao ou veracidade do conteudo do material divulgado. pois trata-se de uma opiniao exclusiva do autor ou fonte mencionada. - Em caso de controversia, as partes elegem o Foro da Comarca de Santos-SP-Brasil, local oficial da empresa proprietaria do Segs e desde ja renunciam expressamente qualquer outro Foro, por mais privilegiado que seja. O Segs trata-se de uma Ferramenta automatizada e controlada por IP. - "Leia e use esta ferramenta, somente se concordar com todos os TERMOS E CONDICOES DE USO".
<::::::::::::::::::::>


Adicionar comentário